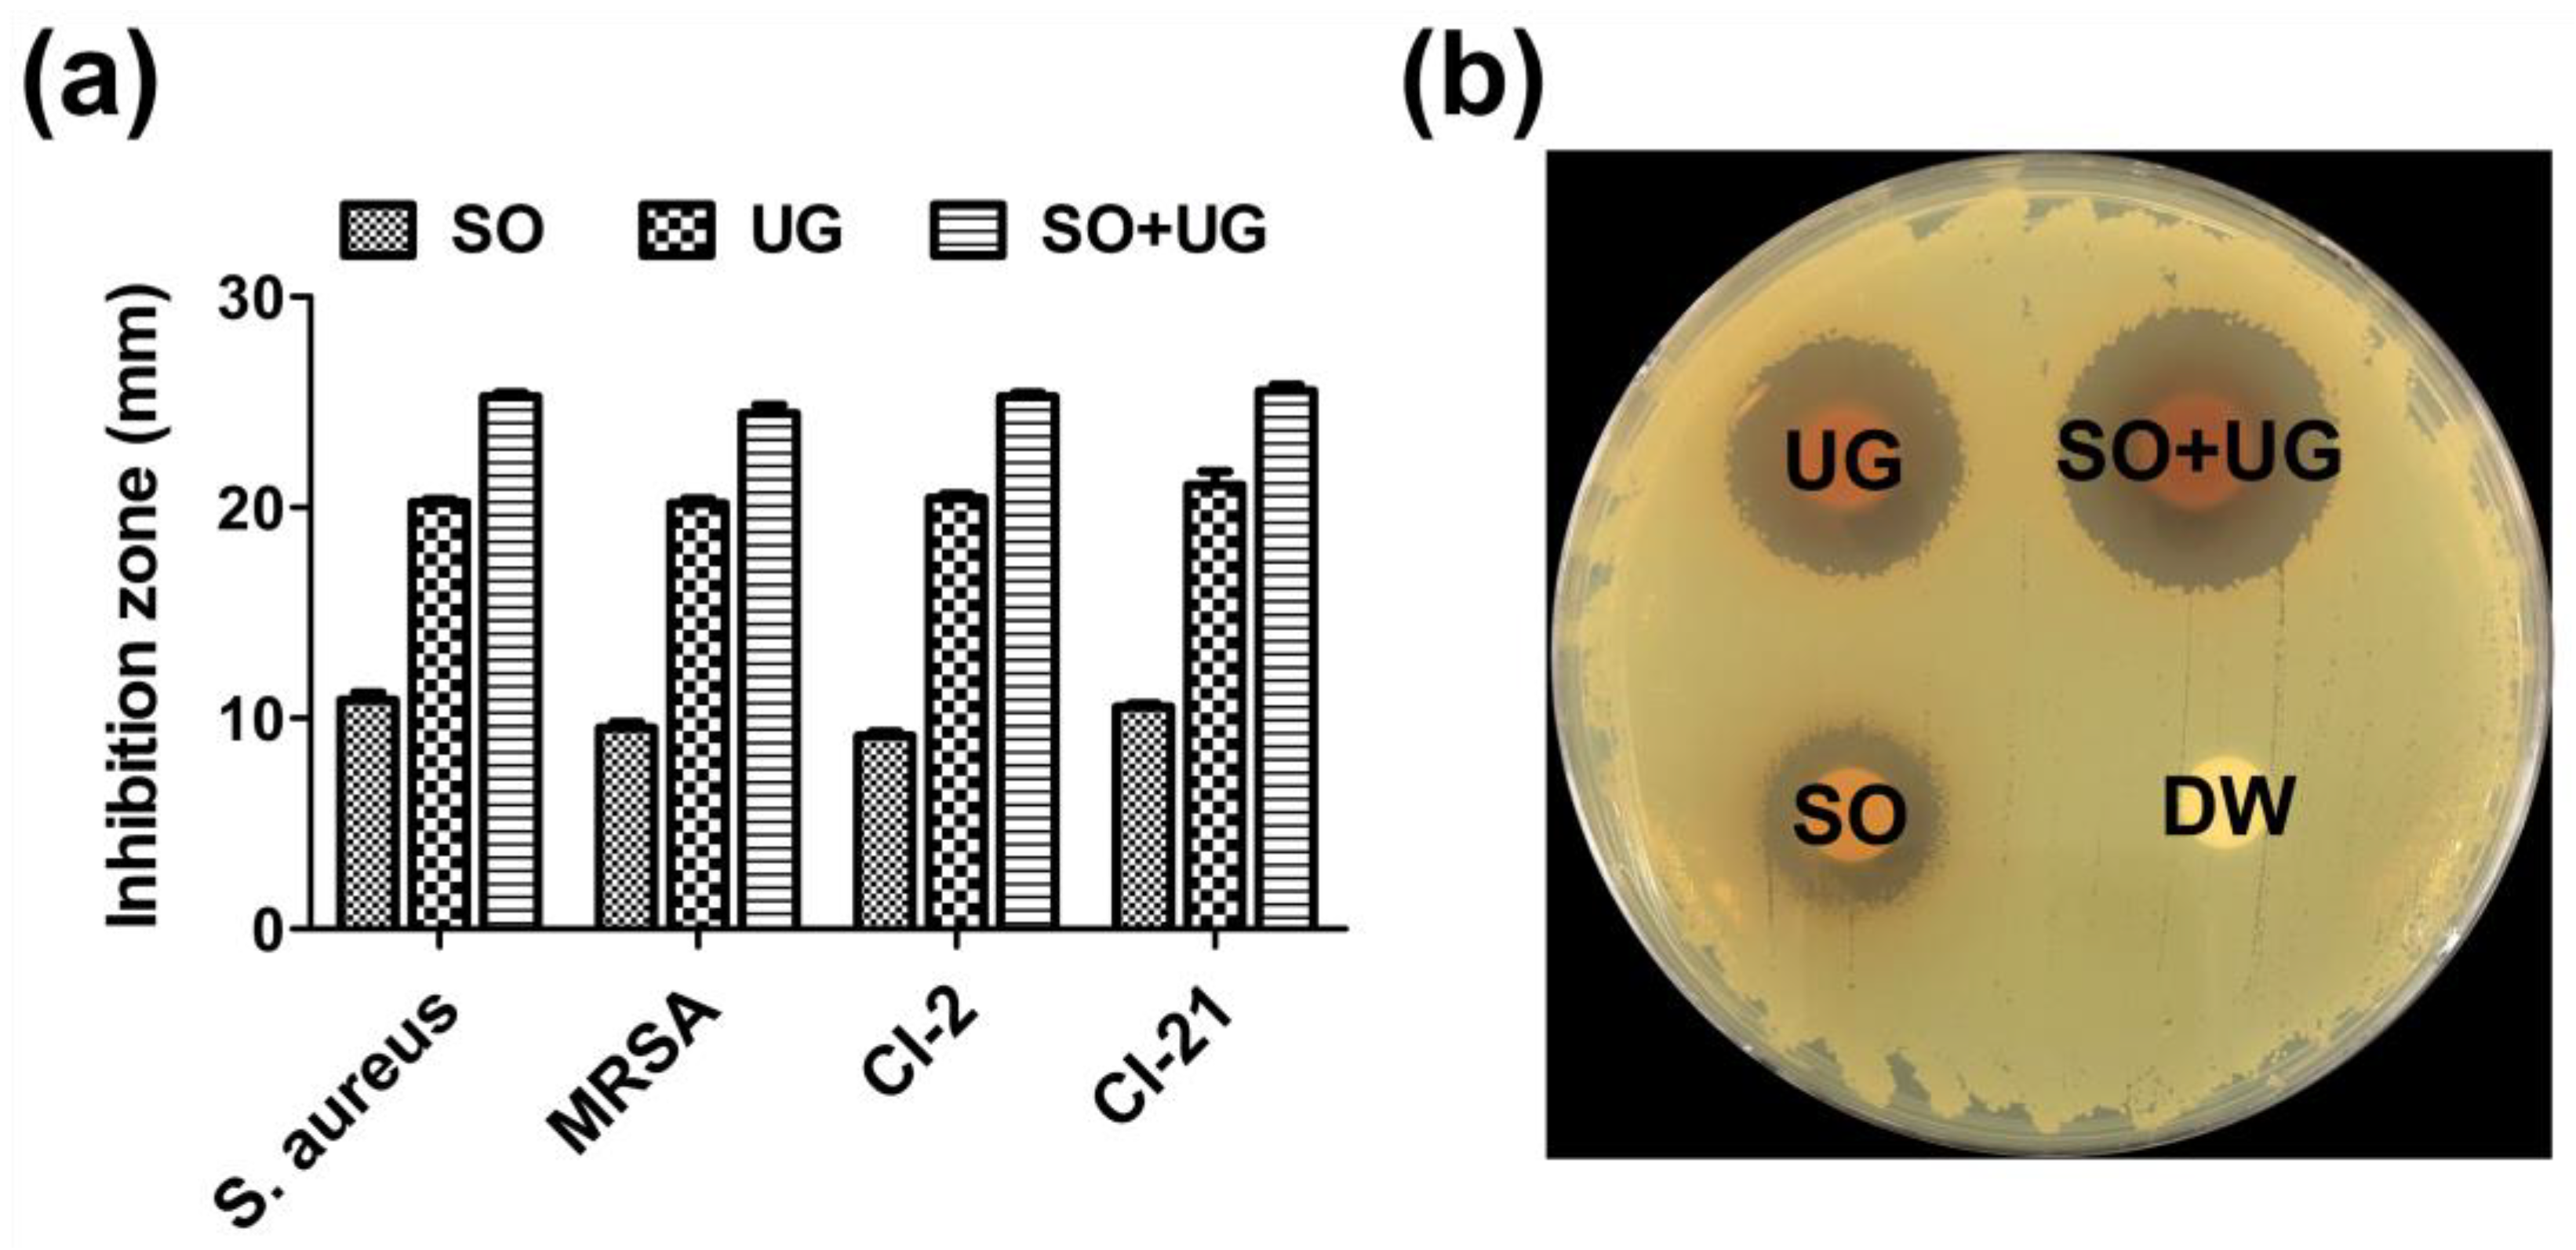
Pharmaceuticals 16 01491 g004

In Vitro Synergistic Inhibitory Effects of Plant Extract Combinations on Bacterial Growth of Methicillin-Resistant Staphylococcus aureus
Abstract
:1. Introduction
2. Results and Discussion
3. Materials and Methods
3.1. Plant Materials
3.2. Preparation of Plant Extracts
3.3. Ultra-Performance Liquid Chromatography (UPLC) Analysis
3.4. Bacterial Culture
3.5. Determination of Minimum Inhibitory Concentration (MIC)
3.6. Determination of Minimum Bactericidal Concentration (MBC)
3.7. Checkerboard Synergy Assay
3.8. Time-Kill Kinetic Analysis
3.9. Disc Diffusion Assay
3.10. MultiStep Resistance Selection against MRSA
3.11. Statistical Analysis
4. Conclusions
Supplementary Materials
Author Contributions
Funding
Institutional Review Board Statement
Informed Consent Statement
Data Availability Statement
Conflicts of Interest
References
- Kim, H.; Park, S.; Seo, H.; Chung, H.; Kim, E.S.; Sung, H.; Kim, M.N.; Bae, S.; Jung, J.; Kim, M.J.; et al. Clinical impact of and microbiological risk factors for qacA/B positivity in ICU-acquired ST5-methicillin-resistant SCCmec type II Staphylococcus aureus bacteremia. Sci. Rep. 2022, 12, 11413. [Google Scholar] [CrossRef]
- Alfouzan, W.; Udo, E.E.; Modhaffer, A.; Alosaimi, A. Molecular Characterization of Methicillin- Resistant Staphylococcus aureus in a Tertiary Care hospital in Kuwait. Sci. Rep. 2019, 9, 18527. [Google Scholar] [CrossRef] [PubMed]
- Zhen, X.; Lundborg, C.S.; Zhang, M.; Sun, X.; Li, Y.; Hu, X.; Gu, S.; Gu, Y.; Wei, J.; Dong, H. Clinical and economic impact of methicillin-resistant Staphylococcus aureus: A multicentre study in China. Sci. Rep. 2020, 10, 3900. [Google Scholar] [CrossRef]
- Li, Y.; Lee, Y.; Seo, Y.; Hwang, Y. Relationship of multidrug-resistant gene and extended-spectrum carbapenem-resistance in Staphylococcus aureus. Biocell 2019, 43, 263–269. [Google Scholar] [CrossRef]
- Moon, H.W.; Kim, H.J.; Hur, M.; Yun, Y.M. Antimicrobial susceptibility profiles of Staphylococcus aureus isolates classified according to their origin in a tertiary hospital in Korea. Am. J. Infect. Control. 2014, 42, 1340–1342. [Google Scholar] [CrossRef]
- Bueno, J. Antimicrobial Adjuvants Drug Discovery, the Challenge of Avoid the Resistance and Recover the Susceptibility of Multidrug-Resistant Strains. J. Microb. Biochem. Technol. 2016, 8, 169–176. [Google Scholar] [CrossRef]
- Loncaric, I.; Tichy, A.; Handler, S.; Szostak, M.P.; Tickert, M.; Diab-Elschahawi, M.; Spergser, J.; Kunzel, F. Prevalence of Methicillin-Resistant Staphylococcus sp. (MRS) in Different Companion Animals and Determination of Risk Factors for Colonization with MRS. Antibiotics 2019, 8, 36. [Google Scholar] [CrossRef]
- Khunbutsri, D.; Naimon, N.; Satchasataporn, K.; Inthong, N.; Kaewmongkol, S.; Sutjarit, S.; Setthawongsin, C.; Meekhanon, N. Antibacterial Activity of Solanum torvum Leaf Extract and Its Synergistic Effect with Oxacillin against Methicillin-Resistant Staphyloccoci Isolated from Dogs. Antibiotics 2022, 11, 302. [Google Scholar] [CrossRef]
- Fergestad, M.E.; Stamsas, G.A.; Morales Angeles, D.; Salehian, Z.; Wasteson, Y.; Kjos, M. Penicillin-binding protein PBP2a provides variable levels of protection toward different beta-lactams in Staphylococcus aureus RN4220. Microbiologyopen 2020, 9, e1057. [Google Scholar] [CrossRef]
- Uc-Cachon, A.H.; Dzul-Beh, A.J.; Palma-Pech, G.A.; Jimenez-Delgadillo, B.; Flores-Guido, J.S.; Gracida-Osorno, C.; Molina-Salinas, G.M. Antibacterial and antibiofilm activities of Mayan medicinal plants against Methicillin-susceptible and -resistant strains of Staphylococcus aureus. J. Ethnopharmacol. 2021, 279, 114369. [Google Scholar] [CrossRef] [PubMed]
- Panda, S.K.; Mohanta, Y.K.; Padhi, L.; Park, Y.H.; Mohanta, T.K.; Bae, H. Large Scale Screening of Ethnomedicinal Plants for Identification of Potential Antibacterial Compounds. Molecules 2016, 21, 293. [Google Scholar] [CrossRef]
- Archana, H.; Geetha Bose, V. Evaluation of phytoconstituents from selected medicinal plants and its synergistic antimicrobial activity. Chemosphere 2022, 287, 132276. [Google Scholar] [CrossRef]
- Robinson, M.M.; Zhang, X. The World Medicines Situation 2011, Traditional Medicines: Global Situation, Issues and Challenges; World Health Organization: Geneva, Switzerland, 2011; pp. 1–4. [Google Scholar]
- Guadie, A.; Dakone, D.; Unbushe, D.; Wang, A.; Xia, S. Antibacterial activity of selected medicinal plants used by traditional healers in Genta Meyche (Southern Ethiopia) for the treatment of gastrointestinal disorders. J. Herb. Med. 2020, 22, 100338. [Google Scholar] [CrossRef]
- Carabajal, M.P.A.; Isla, M.I.; Borsarelli, C.D.; Zampini, I.C. Influence of in vitro gastro-duodenal digestion on the antioxidant activity of single and mixed three “Jarilla” species infusions. J. Herb. Med. 2020, 19, 100296. [Google Scholar] [CrossRef]
- George, B.P.A.; Abrahamse, H.; Hemmaragala, N.M. Caspase dependent apoptotic inhibition of melanoma and lung cancer cells by tropical Rubus extracts. BioMed. Pharmacother. 2016, 80, 193–199. [Google Scholar] [CrossRef] [PubMed]
- Wang, S.; Liu, X.Q.; Kang, O.H.; Kwon, D.Y. Combination of Sanguisorbigenin and Conventional Antibiotic Therapy for Methicillin-Resistant Staphylococcus. aureus: Inhibition of Biofilm Formation and Alteration of Cell Membrane Permeability. Int. J. Mol. Sci. 2022, 23, 4232. [Google Scholar] [CrossRef]
- Ali, H.; Ali, D.; Almutairi, B.O.; Kumar, G.; Karga, G.A.; Masi, C.; Sundramurthy, V.P. Synergistic Effect of Conventional Medicinal Herbs against Different Pharmacological Activity. BioMed. Res. Int. 2022, 2022, 7337261. [Google Scholar] [CrossRef]
- Devanathadesikan Seshadri, V.; Vijayaraghavan, P.; Kim, Y.O.; Kim, H.J.; Ahmed Al-Ghamdi, A.; Elshikh, M.S.; Al-Dosary, M.A.; Alsubaie, Q.D. In vitro antioxidant and cytotoxic activities of polyherbal extracts from Vetiveria zizanioides, Trichosanthes cucumerina, and Mollugo cerviana on HeLa and MCF-7 cell lines. Saudi J. Biol. Sci. 2020, 27, 1475–1481. [Google Scholar] [CrossRef]
- Atta, S.; Waseem, D.; Fatima, H.; Naz, I.; Rasheed, F.; Kanwal, N. Antibacterial potential and synergistic interaction between natural polyphenolic extracts and synthetic antibiotic on clinical isolates. Saudi J. Biol. Sci. 2023, 30, 103576. [Google Scholar] [CrossRef] [PubMed]
- Soulaimani, B.; Varoni, E.; Iriti, M.; Mezrioui, N.E.; Hassani, L.; Abbad, A. Synergistic Anticandidal Effects of Six Essential Oils in Combination with Fluconazole or Amphotericin B against Four Clinically Isolated Candida Strains. Antibiotics 2021, 10, 1049. [Google Scholar] [CrossRef]
- Bittner Fialova, S.; Rendekova, K.; Mucaji, P.; Nagy, M.; Slobodnikova, L. Antibacterial Activity of Medicinal Plants and Their Constituents in the Context of Skin and Wound Infections, Considering European Legislation and Folk Medicine—A Review. Int. J. Mol. Sci. 2021, 22, 10746. [Google Scholar] [CrossRef]
- Sharma, K.; Guleria, S.; Razdan, V.K.; Babu, V. Synergistic antioxidant and antimicrobial activities of essential oils of some selected medicinal plants in combination and with synthetic compounds. Ind. Crops. Prod. 2020, 154, 112569. [Google Scholar] [CrossRef]
- Deciga-Campos, M.; Beltran-Villalobos, K.L.; Aguilar-Mariscal, H.; Gonzalez-Trujano, M.E.; Angeles-Lopez, G.E.; Ventura-Martinez, R. Synergistic Herb-Herb Interaction of the Antinociceptive and Anti-Inflammatory Effects of Syzygium aromaticum and Rosmarinus officinalis Combination. Evid. Based Complement Alternat. Med. 2021, 2021, 8916618. [Google Scholar] [CrossRef]
- Jung, I.G.; Jeong, J.Y.; Yum, S.H.; Hwang, Y.J. Inhibitory Effects of Selected Medicinal Plants on Bacterial Growth of Methicillin-Resistant Staphylococcus aureus. Molecules 2022, 27, 7780. [Google Scholar] [CrossRef] [PubMed]
- Nirmal, N.P.; Rajput, M.S.; Prasad, R.G.; Ahmad, M. Brazilin from Caesalpinia sappan heartwood and its pharmacological activities: A review. Asian. Pac. J. Trop. Med. 2015, 8, 421–430. [Google Scholar] [CrossRef] [PubMed]
- Settharaksa, S.; Monton, C.; Charoenchai, L. Optimization of Caesalpinia sappan L. heartwood extraction procedure to obtain the highest content of brazilin and greatest antibacterial activity. J. Integr. Med. 2019, 17, 351–358. [Google Scholar] [CrossRef]
- He, R.; Ma, T.T.; Gong, M.X.; Xie, K.L.; Wang, Z.M.; Li, J. The correlation between pharmacological activity and contents of eight constituents of Glycyrrhiza uralensis Fisch. Heliyon 2023, 9, e14570. [Google Scholar] [CrossRef]
- Wang, S.; Luo, J.; Liu, X.Q.; Kang, O.H.; Kwon, D.Y. Antibacterial activity and synergy of antibiotics with sanguisorbigenin isolated from Sanguisorba. officinalis L. against methicillin-resistant Staphylococcus aureus. Lett. Appl. Microbiol. 2021, 72, 238–244. [Google Scholar] [CrossRef] [PubMed]
- Munggari, I.P.; Kurnia, D.; Deawati, Y.; Julaeha, E. Current Research of Phytochemical, Medicinal and Non-Medicinal Uses of Uncaria gambir Roxb.: A Review. Molecules 2022, 27, 6551. [Google Scholar] [CrossRef]
- Mueller, M.; Weinmann, D.; Toegel, S.; Holzer, W.; Unger, F.M.; Viernstein, H. Compounds from Caesalpinia sappan with anti-inflammatory properties in macrophages and chondrocytes. Food Funct. 2016, 7, 1671–1679. [Google Scholar] [CrossRef]
- Felipe Gonzalez, A.; Nunez Cairo, C.R.; Gutierrez Gaiten, Y.I.; Scull Lizama, R.; Zumata Dube, M.C.; Docinas, E.I.; Bou, N.P.; Foubert, K.; Pieters, L.; Delgado Hernandez, R. Phytochemical characterisation and in vivo antilithiatic activity of the stems of Caesalpinia bahamensis (Brasilete). Nat. Prod. Res. 2022, 36, 3765–3769. [Google Scholar] [CrossRef] [PubMed]
- Guo, J.Y.; Wang, D.M.; Wang, M.J.; Zhou, J.; Pan, Y.N.; Wang, Z.Z.; Xiao, W.; Liu, X.Q. Systematically characterize the substance basis of Jinzhen oral liquid and their pharmacological mechanism using UPLC-Q-TOF/MS combined with network pharmacology analysis. J. Food. Drug. Anal. 2019, 27, 793–804. [Google Scholar] [CrossRef] [PubMed]
- Wang, H.; Song, W.; Tao, W.; Zhang, J.; Zhang, X.; Zhao, J.; Yong, J.; Gao, X.; Guo, L. Identification wild and cultivated licorice by multidimensional analysis. Food Chem. 2021, 339, 128111. [Google Scholar] [CrossRef] [PubMed]
- Kardel, M.; Taube, F.; Schulz, H.; Schütze, W.; Gierus, M. Different approaches to evaluate tannin content and structure of selected plant extracts–review and new aspects. J. Appl. Bot. Food. Qual. 2013, 86, 154–166. [Google Scholar]
- Sazwi, N.N.; Nalina, T.; Rahim, Z.H.A. Antioxidant and cytoprotective activities of Piper betle, Areca catechu, Uncaria gambir and betel quid with and without calcium hydroxide. BMC Complement. Altern. Med. 2013, 13, 1–2. [Google Scholar]
- Hemeg, H.A.; Moussa, I.M.; Ibrahim, S.; Dawoud, T.M.; Alhaji, J.H.; Mubarak, A.S.; Kabli, S.A.; Alsubki, R.A.; Tawfik, A.M.; Marouf, S.A. Antimicrobial effect of different herbal plant extracts against different microbial population. Saudi J. Biol. Sci. 2020, 27, 3221–3227. [Google Scholar] [CrossRef]
- Pattananandecha, T.; Apichai, S.; Julsrigival, J.; Ogata, F.; Kawasaki, N.; Saenjum, C. Antibacterial Activity against Foodborne Pathogens and Inhibitory Effect on Anti-Inflammatory Mediators’ Production of Brazilin-Enriched Extract from Caesalpinia sappan Linn. Plants 2022, 11, 1698. [Google Scholar] [CrossRef]
- Zuo, G.Y.; Han, Z.Q.; Han, J.; Hao, X.Y.; Tang, H.S.; Wang, G.C. Antimicrobial activity and synergy of antibiotics with two biphenyl compounds, protosappanins A and B from Sappan Lignum against methicillin-resistant Staphylococcus aureus strains. J. Pharm. Pharmacol. 2015, 67, 1439–1447. [Google Scholar] [CrossRef]
- Li, Y.-P.; Yu, C.-X.; Qiao, J.; Zang, Y.-M.; Xiang, Y.; Ren, G.-X.; Wang, L.; Zhang, X.-Y.; Liu, C.-S. Effect of exogenous phytohormones treatment on glycyrrhizic acid accumulation and preliminary exploration of the chemical control network based on glycyrrhizic acid in root of Glycyrrhiza uralensis. Rev. Bras. Farmacogn. 2016, 26, 490–496. [Google Scholar] [CrossRef]
- Oyama, K.; Kawada-Matsuo, M.; Oogai, Y.; Hayashi, T.; Nakamura, N.; Komatsuzawa, H. Antibacterial effects of glycyrrhetinic acid and its derivatives on Staphylococcus aureus. PLoS ONE 2016, 11, e0165831. [Google Scholar] [CrossRef]
- Mita, S.R.; Abdassah, M.; Supratman, U.; Shiono, Y.; Rahayu, D.; Sopyan, I.; Wilar, G. Nanoparticulate System for the Transdermal Delivery of Catechin as an Antihypercholesterol: In Vitro and In Vivo Evaluations. Pharmaceuticals 2022, 15, 1142. [Google Scholar] [CrossRef]
- Sinsinwar, S.; Vadivel, V. Catechin isolated from cashew nut shell exhibits antibacterial activity against clinical isolates of MRSA through ROS-mediated oxidative stress. Appl. Microbiol. Biotechnol. 2020, 104, 8279–8297. [Google Scholar] [CrossRef] [PubMed]
- Veiko, A.G.; Olchowik-Grabarek, E.; Sekowski, S.; Roszkowska, A.; Lapshina, E.A.; Dobrzynska, I.; Zamaraeva, M.; Zavodnik, I.B. Antimicrobial Activity of Quercetin, Naringenin and Catechin: Flavonoids Inhibit Staphylococcus aureus-Induced Hemolysis and Modify Membranes of Bacteria and Erythrocytes. Molecules 2023, 28, 1252. [Google Scholar] [CrossRef] [PubMed]
- Zhai, X.; Wu, G.; Tao, X.; Yang, S.; Lv, L.; Zhu, Y.; Dong, D.; Xiang, H. Success stories of natural product-derived compounds from plants as multidrug resistance modulators in microorganisms. RSC. Adv. 2023, 13, 7798–7817. [Google Scholar] [CrossRef] [PubMed]
- Jang, E.; Inn, K.S.; Jang, Y.P.; Lee, K.T.; Lee, J.H. Phytotherapeutic Activities of Sanguisorba officinalis and its Chemical Constituents: A Review. Am. J. Chin. Med. 2018, 46, 299–318. [Google Scholar] [CrossRef]
- Rady, O.; El-Attar, L.; Amine, A. In vitro synergistic activity of colistin and teicoplanin combination against multidrug-resistant Acinetobacter spp. J. Antibiot. 2022, 75, 181–184. [Google Scholar] [CrossRef]
- Saiful, A.J.; Mastura, M.; Zarizal, S.; Mazurah, M.I.; Shuhaimi, M.; Ali, A.M. Detection of methicillin-resistant Staphylococcus aureus using mecA/nuc genes and antibiotic susceptibility profile of Malaysian clinical isolates. World J. Microbiol. Biotechnol. 2006, 22, 1289–1294. [Google Scholar] [CrossRef]
- Kim, G.; Gan, R.Y.; Zhang, D.; Farha, A.K.; Habimana, O.; Mavumengwana, V.; Li, H.B.; Wang, X.H.; Corke, H. Large-Scale Screening of 239 Traditional Chinese Medicinal Plant Extracts for Their Antibacterial Activities against Multidrug-Resistant Staphylococcus aureus and Cytotoxic Activities. Pathogens 2020, 9, 185. [Google Scholar] [CrossRef]
- Alvarez-Martinez, F.J.; Barrajon-Catalan, E.; Herranz-Lopez, M.; Micol, V. Antibacterial plant compounds, extracts and essential oils: An updated review on their effects and putative mechanisms of action. Phytomedicine 2021, 90, 153626. [Google Scholar] [CrossRef]
- Gufe, C.; Mugabe, T.N.; Makuvara, Z.; Marumure, J.; Benard, M. In-vitro assessment of the efficacy of herb-herb combinations against multidrug-resistant mastitis-causing bacteria: Staphylococcus aureus and Klebsiella pneumoniae. Cogent Food Agric. 2023, 9, 12187250. [Google Scholar] [CrossRef]
- Idowu, O.A.; Babalola, A.S.; Olukunle, J. Antagonistic effects of some commonly used herbs on the efficacy of Artemisinin derivatives in the treatment of malaria in experimental mice. Bull. Natl. Res. Cent. 2020, 44, 1–8. [Google Scholar] [CrossRef]
- Masoumian, M.; Zandi, M. Antimicrobial Activity of Some Medicinal Plant Extracts against Multidrug Resistant Bacteria. Zahedan J. Res. Med. Sci. 2017, 19, e10080. [Google Scholar] [CrossRef]
- Suberu, J.O.; Gorka, A.P.; Jacobs, L.; Roepe, P.D.; Sullivan, N.; Barker, G.C.; Lapkin, A.A. Anti-Plasmodial Polyvalent Interactions in Artemisia. annua L. Aqueous Extract—Possible Synergistic and Resistance Mechanisms. PLoS ONE 2013, 8, e80790. [Google Scholar] [CrossRef]
- Zheng, Y.; Lee, S.Y.; Lee, Y.; Lee, T.K.; Kim, J.E.; Kim, T.H.; Kang, I.J. Standardized Sanguisorba officinalis L. Extract Inhibits Adipogenesis and Promotes Thermogenesis via Reducing Oxidative Stress. Antioxidants 2023, 12, 882. [Google Scholar] [CrossRef] [PubMed]
- Anggraini, T.; Tai, A.; Yoshino, T.; Itani, T. Antioxidative activity and catechin content of four kinds of Uncaria gambir extracts from West Sumatra, Indonesia. Afr. J. Biochem. Res. 2011, 5, 33–38. [Google Scholar]
- Adnan, M.; Patel, M.; Deshpande, S.; Alreshidi, M.; Siddiqui, A.J.; Reddy, M.N.; Emira, N.; De Feo, V. Effect of Adiantum philippense Extract on Biofilm Formation, Adhesion with Its Antibacterial Activities Against Foodborne Pathogens, and Characterization of Bioactive Metabolites: An in vitro-in silico Approach. Front. Microbiol. 2020, 11, 823. [Google Scholar] [CrossRef]
- Pietschmann, S.; Meyer, M.; Voget, M.; Cieslicki, M. The joint in vitro action of polymyxin B and miconazole against pathogens associated with canine otitis externa from three European countries. Vet. Dermatol. 2013, 24, 439–445, e96-7. [Google Scholar] [CrossRef]
- Naim, N.; Bouymajane, A.; Oulad El Majdoub, Y.; Ezrari, S.; Lahlali, R.; Tahiri, A.; Ennahli, S.; Lagana Vinci, R.; Cacciola, F.; Mondello, L.; et al. Flavonoid Composition and Antibacterial Properties of Crocus sativus L. Petal Extracts. Molecules 2022, 28, 186. [Google Scholar] [CrossRef]
- Manilal, A.; Sabu, K.R.; Shewangizaw, M.; Aklilu, A.; Seid, M.; Merdikios, B.; Tsegaye, B. In vitro antibacterial activity of medicinal plants against biofilm-forming methicillin-resistant Staphylococcus aureus: Efficacy of Moringa stenopetala and Rosmarinus officinalis extracts. Heliyon 2020, 6, e03303. [Google Scholar] [CrossRef]
- Elshikh, M.; Ahmed, S.; Funston, S.; Dunlop, P.; McGaw, M.; Marchant, R.; Banat, I.M. Resazurin-based 96-well plate microdilution method for the determination of minimum inhibitory concentration of biosurfactants. Biotechnol. Lett. 2016, 38, 1015–1019. [Google Scholar] [CrossRef]
- Ren, L.; Hemar, Y.; Perera, C.O.; Lewis, G.; Krissansen, G.W.; Buchanan, P.K. Antibacterial and antioxidant activities of aqueous extracts of eight edible mushrooms. Bioact. Carbohydr. Diet. Fibre 2014, 3, 41–51. [Google Scholar] [CrossRef]
- Ukuhor, H.O. The interrelationships between antimicrobial resistance, COVID-19, past, and future pandemics. J. Infect. Public. Health 2021, 14, 53–60. [Google Scholar] [CrossRef] [PubMed]
- Schrader, S.M.; Botella, H.; Jansen, R.; Ehrt, S.; Rhee, K.; Nathan, C.; Vaubourgeix, J. Multiform antimicrobial resistance from a metabolic mutation. Sci. Adv. 2021, 7, eabh2037. [Google Scholar] [CrossRef] [PubMed]
- Rivas-Caceres, R.R.; Luis Stephano-Hornedo, J.; Lugo, J.; Vaca, R.; Del Aguila, P.; Yanez-Ocampo, G.; Mora-Herrera, M.E.; Camacho Diaz, L.M.; Cipriano-Salazar, M.; Alaba, P.A. Bactericidal effect of silver nanoparticles against the propagation of Clavibacter michiganensis infection in Lycopersicon esculentum Mill. Microb. Pathog. 2018, 115, 358–362. [Google Scholar] [CrossRef] [PubMed]
- Mun, Y.S.; Hwang, Y.J. Novel spa and Multi-Locus Sequence Types (MLST) of Staphylococcus aureus Samples Isolated from Clinical Specimens in Korean. Antibiotics 2019, 8, 202. [Google Scholar] [CrossRef]
- Bostanci, M.T.; Bulbul, A.S.; Celik, I.S.; Kocabas, Y.Z.; Burhan, H.; Bayat, R.; Sen, F.; Zakariae, N.; Esmaeili, R.; Jafari, H.; et al. Investigation of antibacterial, antifungal, antibiofilm, antioxidant and anticancer properties of methanol extracts of Salvia marashica Ilcim, Celep & Dogan and Salvia caespitosa Montbret & Aucher ex. Benth plants with medicinal importance. Chemosphere 2022, 288, 132602. [Google Scholar] [PubMed]
- Chraibi, M.; Farah, A.; Elamin, O.; Iraqui, H.M.; Fikri-Benbrahim, K. Characterization, antioxidant, antimycobacterial, antimicrobial effcts of Moroccan rosemary essential oil, and its synergistic antimicrobial potential with carvacrol. J. Adv. Pharm. Technol. Res. 2020, 11, 25–29. [Google Scholar]
- Sharaf, M.H.; El-Sherbiny, G.M.; Moghannem, S.A.; Abdelmonem, M.; Elsehemy, I.A.; Metwaly, A.M.; Kalaba, M.H. New combination approaches to combat methicillin-resistant Staphylococcus aureus (MRSA). Sci. Rep. 2021, 11, 4240. [Google Scholar] [CrossRef]
- Bauer, A.W.; Kirby, W.M.; Sherris, J.C.; Turck, M. Antibiotic susceptibility testing by a standardized single disk method. Am. J. Clin. Pathol. 1966, 45, 493–496. [Google Scholar] [CrossRef]
- Mohammad, H.; Younis, W.; Ezzat, H.G.; Peters, C.E.; AbdelKhalek, A.; Cooper, B.; Pogliano, K.; Pogliano, J.; Mayhoub, A.S.; Seleem, M.N. Bacteriological profiling of diphenylureas as a novel class of antibiotics against methicillin-resistant Staphylococcus aureus. PLoS ONE 2017, 12, e0182821. [Google Scholar] [CrossRef]

| Scientific Name | Common Name | Family | Parts Used | Origin | Pharmacological Uses |
|---|---|---|---|---|---|
| Caesalpinia sappan L. | Sappan wood | Leguminosae | Heartwood | Indonesia | Pulmonary hemorrhage and skin diseases, antibacterial, antioxidant, anti-inflammatory, hemostatic, and hepatoprotective [26,27] |
| Glycyrrhiza uralensis Fisch. | Chinese liquorice | Fabaceae | Roots | China | Respiratory and liver diseases, inflammation, antioxidant, immunoregulatory, antivirus, and antimicrobial [28] |
| Sanguisorba officinalis L. | Greater burnet | Rosaceae | Roots | China | Astringent bleeding and allergic skin diseases, anti-inflammatory, antiviral, anticancer, and antibacterial [29] |
| Uncaria gambir Roxb. | Gambir | Rubiaceae | Leaves and twigs | Indonesia | Fever and cough, bacterial/fungal infections, diabetes, inflammation, and cancer [30] |
| No. | Medicinal Plants | RT (min) | [M−H]− m/z | Molecular Formula | Tentative Identification |
|---|---|---|---|---|---|
| 1 | CS | 2.98 | 285.07 | C16H14O5 | Brazilin |
| 2 | CS | 3.10 | 303.08 | C16H16O6 | Protosappanin B |
| 3 | GU | 4.35 | 549.16 | C26H30O13 | Liquiritin apioside |
| 4 | GU | 9.48 | 821.40 | C42H62O16 | Glycyrrhizin |
| 5 | UG | 3.07 | 289.07 | C15H14O6 | Catechin |
| Medicinal Plants | MIC Values (μg/mL) | |||
|---|---|---|---|---|
| Bacterial Strains | ||||
| S. aureus 29,213 | MRSA 33,591 | CI-2 | CI-21 | |
| CS | 62.5 | 62.5 | 62.5 | 62.5 |
| GU | 250 | 250 | 250 | 250 |
| SO | 250 | 250 | 250 | 250 |
| UG | 250 | 250 | 250 | 250 |
| Bacterial Strains | Medicinal Plants | FIC Values | FIC Index | Interpretation | ||
|---|---|---|---|---|---|---|
| A | B | FICA | FICB | |||
| S. aureus 29,213 | CS | GU | 0.125 | 0.5 | 0.625 | Partial synergy |
| CS | SO | 0.125 | 0.5 | 0.625 | Partial synergy | |
| CS | UG | 0.125 | 0.5 | 0.625 | Partial synergy | |
| GU | SO | 0.5 | 0.5 | 1 | Additive | |
| GU | UG | 0.5 | 0.125 | 0.625 | Partial synergy | |
| 0.125 | 0.5 | 0.625 | Partial synergy | |||
| SO | UG | 0.25 | 0.25 | 0.5 | Synergistic | |
| MRSA 33,591 | CS | GU | 0.125 | 0.5 | 0.625 | Partial synergy |
| CS | SO | 0.125 | 0.5 | 0.625 | Partial synergy | |
| CS | UG | 0.125 | 0.5 | 0.625 | Partial synergy | |
| GU | SO | 0.5 | 0.5 | 1 | Additive | |
| GU | UG | 0.5 | 0.125 | 0.625 | Partial synergy | |
| 0.125 | 0.5 | 0.625 | Partial synergy | |||
| SO | UG | 0.25 | 0.25 | 0.5 | Synergistic | |
| CI-2 | CS | GU | 0.125 | 0.5 | 0.625 | Partial synergy |
| CS | SO | 0.125 | 0.5 | 0.625 | Partial synergy | |
| CS | UG | 0.125 | 0.5 | 0.625 | Partial synergy | |
| GU | SO | 0.5 | 0.5 | 1 | Additive | |
| GU | UG | 0.5 | 0.125 | 0.625 | Partial synergy | |
| 0.125 | 0.5 | 0.625 | Partial synergy | |||
| SO | UG | 0.25 | 0.25 | 0.5 | Synergistic | |
| CI-21 | CS | GU | 0.125 | 0.5 | 0.625 | Partial synergy |
| CS | SO | 0.125 | 0.5 | 0.625 | Partial synergy | |
| CS | UG | 0.125 | 0.5 | 0.625 | Partial synergy | |
| GU | SO | 0.5 | 0.5 | 1 | Additive | |
| GU | UG | 0.5 | 0.125 | 0.625 | Partial synergy | |
| 0.125 | 0.5 | 0.625 | Partial synergy | |||
| SO | UG | 0.25 | 0.25 | 0.5 | Synergistic | |
Disclaimer/Publisher’s Note: The statements, opinions and data contained in all publications are solely those of the individual author(s) and contributor(s) and not of MDPI and/or the editor(s). MDPI and/or the editor(s) disclaim responsibility for any injury to people or property resulting from any ideas, methods, instructions or products referred to in the content. |
© 2023 by the authors. Licensee MDPI, Basel, Switzerland. This article is an open access article distributed under the terms and conditions of the Creative Commons Attribution (CC BY) license (https://creativecommons.org/licenses/by/4.0/).
Share and Cite
Jeong, J.-Y.; Jung, I.-G.; Yum, S.-H.; Hwang, Y.-J. In Vitro Synergistic Inhibitory Effects of Plant Extract Combinations on Bacterial Growth of Methicillin-Resistant Staphylococcus aureus. Pharmaceuticals 2023, 16, 1491. https://doi.org/10.3390/ph16101491
Jeong J-Y, Jung I-G, Yum S-H, Hwang Y-J. In Vitro Synergistic Inhibitory Effects of Plant Extract Combinations on Bacterial Growth of Methicillin-Resistant Staphylococcus aureus. Pharmaceuticals. 2023; 16(10):1491. https://doi.org/10.3390/ph16101491
Chicago/Turabian StyleJeong, Jae-Young, In-Geun Jung, Seung-Hoon Yum, and You-Jin Hwang. 2023. "In Vitro Synergistic Inhibitory Effects of Plant Extract Combinations on Bacterial Growth of Methicillin-Resistant Staphylococcus aureus" Pharmaceuticals 16, no. 10: 1491. https://doi.org/10.3390/ph16101491
APA StyleJeong, J.-Y., Jung, I.-G., Yum, S.-H., & Hwang, Y.-J. (2023). In Vitro Synergistic Inhibitory Effects of Plant Extract Combinations on Bacterial Growth of Methicillin-Resistant Staphylococcus aureus. Pharmaceuticals, 16(10), 1491. https://doi.org/10.3390/ph16101491

